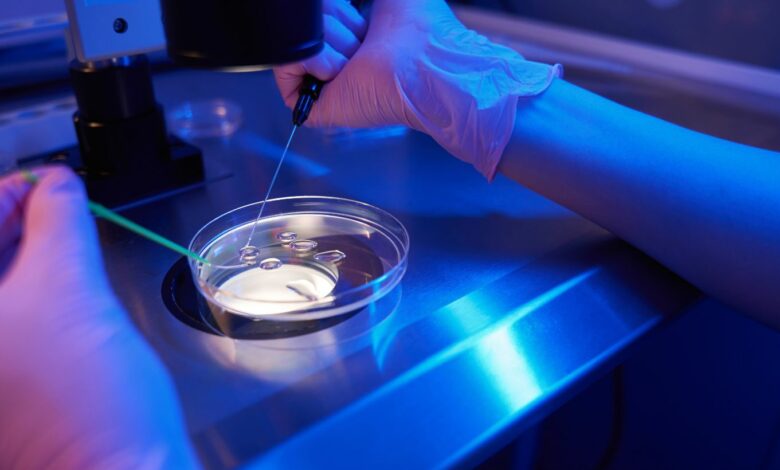

«Γονίδιο του καρκίνου»: Τι αποκαλύπτει καθηγήτρια Γενετικής για τον Δανό δότη
Η αποκάλυψη ότι σπέρμα δότη από τη Δανία με σοβαρή παθογόνο μετάλλαξη στο ογκοκατασταλτικό γονίδιο TP53, που αυξάνει τον κίνδυνο εμφάνισης καρκίνου, χρησιμοποιήθηκε επί χρόνια για τη γέννηση σχεδόν 200 παιδιών σε 14 χώρες -μεταξύ αυτών και 18 στην Ελλάδα- έχει σημάνει παγκόσμια ανησυχία.
Με 11 οικογένειες στη χώρα μας να βρίσκονται σήμερα σε αγωνία και την έρευνα να συνεχίζεται, οι αρμόδιες Αρχές προσπαθούν να χαρτογραφήσουν πλήρως τα περιστατικά. Όπως έκανε γνωστό ο καθηγητής Αιματολογίας-Ογκολογίας του νοσοκομείου Παίδων «Αγία Σοφία», Αντώνης Καττάμης, σύμφωνα με τα έως τώρα στοιχεία, ένα παιδί που γεννήθηκε από το γενετικό υλικό τού δότη έχει χάσει τη ζωή του, ενώ από καρκίνο νοσεί και το αδερφάκι του. Το ζευγάρι απέκτησε τρία παιδιά με σπέρμα τού δότη από τη Δανία.
Σύμφωνα με ειδικούς επιστήμονες, η υπόθεση αποκαλύπτει πως ακόμη και τα αυστηρά πρωτόκολλα δεν μπορούν να μηδενίσουν πλήρως το ρίσκο. Την ίδια ώρα, η συζήτηση για τον αριθμό των παιδιών που μπορεί να γεννηθούν από έναν δότη ανοίγει ξανά, υπογραμμίζοντας την ανάγκη για σταθερούς, διεθνείς κανόνες που θα διασφαλίζουν τη μέγιστη δυνατή ασφάλεια για τα παιδιά και τους γονείς.
Για το σοβαρό αυτό ζήτημα, που έχει προκαλέσει έντονη ανησυχία σε οικογένειες και επιστημονική κοινότητα σε όλη την Ευρώπη, το ΑΠΕ-ΜΠΕ μίλησε στην ομότιμη καθηγήτρια Γενετικής, Ιατρική Σχολή ΕΚΠΑ, Jan Traeger- Συνοδινού, πρώην διευθύντριας Εργαστηρίου Ιατρικής Γενετικής, τακτικό μέλος της Εθνικής Αρχής Ιατρικώς Υποβοηθούμενης Αναπαραγωγής (2021-2024), προκειμένου να αποσαφηνίσει τους πραγματικούς κινδύνους, τα όρια των γενετικών ελέγχων και τα κενά που ανέδειξε η υπόθεση του δότη με τη μετάλλαξη στο TP53.
Τι ισχύει σήμερα στην Ελλάδα
Η καθηγήτρια εξηγεί τι ισχύει σήμερα στην Ελλάδα για τους ελέγχους των δοτών και τον αριθμό χρήσεων των γαμετών, αλλά και γιατί, παρά τα πρωτόκολλα, δεν μπορεί ποτέ να αποκλειστεί πλήρως ο κίνδυνος εμφάνισης μιας σπάνιας γενετικής νόσου.
«Πρώτα απ’ όλα, αυτή η υπόθεση είναι εξαιρετικά δυσάρεστη για όλες τις οικογένειες που έχουν επηρεαστεί. Παράλληλα, αναδεικνύει ορισμένους από τους κινδύνους της εξωσωματικής γονιμοποίησης (IVF), που σχετίζονται:
α) με τη μετάδοση γενετικών νοσημάτων στους απογόνους και
β) με το πόσες φορές επιτρέπεται να χρησιμοποιηθούν τα γαμετικά κύτταρα ενός δότη», αναφέρει η κυρία Traeger- Συνοδινού.
Τι σημαίνει η παραλλαγή στο γονίδιο TP53
«Η παραλλαγή στο συγκεκριμένο ογκογονίδιο χαρακτηρίζεται ως “παθογόνος” βάσει των κριτηρίων της ACMG (Αμερικανικό Κολλέγιο Ιατρικής Γενετικής). Η μετάλλαξη προέκυψε αυτόματα κατά την εμβρυϊκή ανάπτυξη του δότη και δεν βρίσκεται σε όλα τα κύτταρά του (μωσαϊκισμός). Ωστόσο, εκτιμάται ότι περίπου το 20% των κυττάρων του -συμπεριλαμβανομένων των σπερματοζωαρίων- φέρει την παραλλαγή. Κατά συνέπεια, οποιοδήποτε παιδί προκύψει μετά από διαδικασία IVF, με «επηρεασμένο» σπερματοζωάριο θα κληρονομήσει την παραλλαγή σε όλα του τα κύτταρα, γεγονός που συνεπάγεται πολύ υψηλό κίνδυνο εμφάνισης πολλών τύπων καρκίνου, όπως π.χ. στο σύνδρομο Li-Fraumeni. Ακόμη και ο ίδιος ο δότης έχει αυξημένο κίνδυνο εμφάνισης καρκίνου κάποια στιγμή στη ζωή του».
Σε ερώτηση αν η μετάλλαξη ήταν δυνατόν να ανιχνευθεί προληπτικά, η καθηγήτρια Jan Traeger- Συνοδινού απαντά:
«Η τυπική πηγή DNA για γενετικό έλεγχο είναι τα λευκά αιμοσφαίρια από δείγμα ολικού αίματος. Όλες οι διαγνωστικές πλατφόρμες έχουν ρυθμιστεί να ανιχνεύουν παραλλαγές σε επίπεδο περίπου 50%, με κατώτατο όριο ευαισθησίας γύρω στο 30%. Συνεπώς, οι συνηθισμένες εξετάσεις DNA δεν έχουν την ευαισθησία να ανιχνεύσουν τη συγκεκριμένη παραλλαγή στο TP53.
Σε πρακτικό επίπεδο, τόσο υψηλή ευαισθησία δεν απαιτείται – οι κλινικά σημαντικοί μωσαϊκισμοί είναι εξαιρετικά σπάνιοι. Ο συγκεκριμένος δότης αποτελεί εξαιρετικά ασυνήθη περίπτωση, και δεν είναι ρεαλιστικό να εφαρμόζονται τόσο εξειδικευμένες εξετάσεις στην καθημερινή πρακτική».
Ποιοι γενετικοί έλεγχοι πρέπει να πραγματοποιούνται στους δότες γαμετών
Οι απαιτούμενοι έλεγχοι καθορίζονται από το εκάστοτε νομικό πλαίσιο, αν και είναι παρόμοιοι σε όλη την Ευρώπη. Περιλαμβάνουν κατ’ ελάχιστον:
* κλινική και ψυχολογική αξιολόγηση,
* αποκλεισμό βασικών λοιμώξεων,
* γενετικό έλεγχο, ο οποίος μπορεί να είναι περιορισμένος (π.χ. στο Ηνωμένο Βασίλειο μόνο για κυστική ίνωση) ή εκτενέστερος.
Στην Ελλάδα ο έλεγχος περιλαμβάνει ενδεικτικά:
* φορεία μεσογειακής και δρεπανοκυτταρικής αναιμίας,
* φορεία κυστικής ίνωσης (με κάλυψη ≥99% των παθολογικών παραλλαγών),
* κλασικό καρυότυπο,
* φορεία νωτιαίας μυϊκής ατροφίας (γονίδιο SMN1),
* φορεία μη συνδρομικής κώφωσης (γονίδιο GJB2, κονεξίνη),
* για δότριες: έλεγχο φορείας συνδρόμου εύθραυστου Χ (Fragile-X).
«Το ζευγάρι μπορεί να επιλέξει εκτενέστερο γενετικό έλεγχο, αλλά πάντοτε παραμένει ένα μικρό υπολειπόμενο ρίσκο για εξαιρετικά σπάνιες νόσους», αναφέρει, στη δημοσιογράφο του ΑΠΕ-ΜΠΕ, Έφη Φουσέκη, η Jan Traeger- Συνοδινού.
Σημειώνει επίσης, ότι «τα περισσότερα γενετικά νοσήματα μεταδίδονται ως αυτοσωματικά υπολειπόμενα, με κίνδυνο 25% όταν και οι δύο γονείς είναι φορείς (π.χ. κυστική ίνωση, μεσογειακή αναιμία). Άλλα είναι φυλοσύνδετα υπολειπόμενα (μεταδίδονται από μητέρα-φορέα σε γιους με κίνδυνο 50%). Τα αυτοσωματικά επικρατή νοσήματα προκαλούν συνήθως νόσο στον ενήλικα φορέα-οπότε ένα τέτοιο άτομο δεν θα γινόταν δεκτό ως δότης».
Στην Ελλάδα, ο συνιστώμενος μοριακός έλεγχος για αυτοσωματικά υπολειπόμενα νοσήματα περιορίζει σημαντικά την εμφάνιση συχνών σοβαρών γενετικών παθήσεων στους απογόνους. Ο πιο εκτεταμένος έλεγχος παραμένει προαιρετικός, εξηγεί η ομότιμη καθηγήτρια Γενετικής, Ιατρική Σχολή ΕΚΠΑ.
Μέγιστος αριθμός απογόνων ανά δότη
Ερωτηθείς για τον αριθμό χρήσεων των γαμετών από έναν δότη η καθηγήτρια Jan Traeger- Συνοδινού, υπογραμμίζει ότι «στόχος είναι η ελαχιστοποίηση του κινδύνου τυχαίας συγγένειας στο μέλλον». Προσθέτει ότι η ESHRE (European Society of Human Reproduction and Embryology) εκπονεί νέες διεθνείς κατευθυντήριες οδηγίες σχετικά με τον μέγιστο αριθμό απογόνων ανά δότη.
Στην Ελλάδα, σημειώνει, ισχύει νομοθεσία από το 2005 (με πρόσφατες τροποποιήσεις), η οποία ορίζει ότι τα γαμετικά κύτταρα κάθε δότη μπορούν να χρησιμοποιηθούν σε έως 12 οικογένειες συνολικά.
Από το 2022 λειτουργεί επίσης Εθνικό Μητρώο Δοτών Γαμετών, που συμβάλλει στον έλεγχο:
* του αριθμού των απογόνων ανά δότη
* του κινδύνου χρήσης γαμετών που ενδέχεται αργότερα να συσχετιστούν με κάποια γενετική νόσο.
«Η συγκεκριμένη υπόθεση υπενθυμίζει ότι πάντα υπάρχει κίνδυνος εμφάνισης γενετικών παθήσεων-τόσο στη φυσική σύλληψη όσο και στην υποβοηθούμενη αναπαραγωγή. Τα ζευγάρια πρέπει να ενημερώνονται επαρκώς από ειδικούς γενετιστές και να έχουν στη διάθεσή τους επιλογές που μειώνουν αυτόν τον κίνδυνο. Επιπλέον, καθίσταται σαφές ότι όλες οι χώρες οφείλουν να εφαρμόζουν αυστηρά όρια στον αριθμό απογόνων ανά δότη», καταλήγει η ομότιμη καθηγήτρια Γενετικής, Ιατρική Σχολή ΕΚΠΑ, Jan Traeger- Συνοδινού.
Διαβάστε επίσης:
Ένα παιδί που έφερε το «γονίδιο του καρκίνου» έχει ήδη πεθάνει στην Ελλάδα – Έξι σε παρακολούθηση
Σισμανόγλειο: «Δεν υπήρξε περιστατικό κατάποσης φαρμάκου από νοσηλεύτρια»
Παθήσεις Μαστού: Η σημασία της πρόληψης








